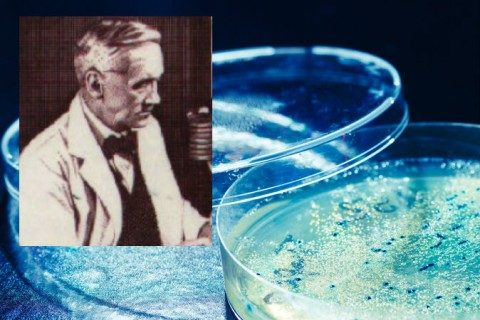

Впечатляющие совпадения
Вселенная полна тайн, которые бросают вызов нашим представлениям о ней. Вот некоторые рассказы об этих странных явлениях, поражающих воображение и открывающих ранее невообразимые возможности. Правдивы ли эти истории? Вам решать.

Обозреватель научно-популярного журнала Scientific American скептик доктор Майкл Шермер описал случай из собственной жизни, который изумил его, и в котором фигурировал транзисторный приемник покойного деда его жены.
Доктор Бернард Бейтман является отцом-основателем Coincidence Studies. В рамках программы Университета Вирджинии он разрабатывает терминологию и методику для изучения совпадений, и в целом делает этот увлекательный феномен, по его словам, “более наукообразным”.
Он слышал огромное множество историй о совпадениях и делится многими из них в ходе своих исследований. Вот несколько особенных примеров.
1. Судьбоносная находка
Когда журналист Стивен Даймонд приехал в Сан-Франциско, у него в кармане было всего 10 долларов. Он не мог позволить себе даже блокнот для записей, а тем временем вдохновение било через край. Он решил, было, украсть блокнот, но передумал. Внезапно он заметил то, в чем так сильно нуждался: блокнот, лежащий лицевой стороной вниз на груде мусора, одежды, обуви, старых книг. Заголовок на блокноте гласил “Стивен Даймонд, Доктор Медицины”. Каковы были шансы Даймонда найти в мусоре блокнот с собственным именем на обложке, да еще в идеальном состоянии, когда он больше всего был нужен? Так в свет вышел культовый роман “What the Trees Said”.
2. Невероятное совпадение поражает скептика

Доктор Майкл Шермер является основателем журнала Skeptic, исполнительным директором организации Skeptics Society и ежемесячным обозревателем журнала Scientific American. Он написал в своей колонке 16 сентября о неком событии, которое привело его к выводу, что не следует закрывать свое восприятие, ведь оно может подарить нам удивительные открытия.
Багаж его невесты был переправлен в Соединенные Штаты из Германии, и среди прочего там был старый транзисторный радиоприемник ее дедушки. Девушка была очень близка со своим дедом, который умер, когда ей было 16. Радио молчало на протяжении десятилетий, и Шермер, как ни старался, не мог заставить его снова заработать. Оно по-прежнему хранило молчание глубоко в ящике стола в спальне супругов. В июне этого года они поженились. После церемонии жена Шермана попросила его поговорить с ней наедине. Она чувствовала себя одиноко, скучала по своей семье в Германии и жалела, что дедушка не дожил до свадьбы и не смог выдать ее замуж. Внезапно из глубины дома молодые услышали музыку, это была романтическая мелодия. Они тщетно искали источник музыки, и вдруг его жена испуганно взглянула на него. ‘Это не может быть то, о чем я думаю, правда?’ – спросила она. Это был транзисторный радиоприемник в ящике. “Мой дедушка здесь с нами”, – сказала она, со слезами на глазах. “Я не одна”. Радио продолжало работать всю брачную ночь.
“Что примечательно, наутро оно перестало играть и молчит по сей день,” пишет Шермер.
3. В нужное время в нужном месте

Александр Флеминг, открывший пенициллин. (фон: чашка Петри с плесенью )
Пенициллин, антибиотик, совершивший огромный прорыв в борьбе с бактериальными инфекциями, был обнаружен после многих лет благодаря многим случайностям и совпадениям.
Шотландский бактериолог Александр Флеминг был простужен в ноябре 1921 года. От насморка с его носа упала капля прямо в чашку для культивирования, полную бактерий. Ученый понял, что эта капля убила бактерии и оставила вокруг себя ореол ингибирования. Компонентом той слизи, что убила бактерии, был лизоцим, однако его нельзя было массово производить в качестве антибиотика.
Почти десять лет спустя Флеминг проводил исследования в больнице Святой Марии. Лабораторные условия были неудовлетворительны – трещины в потолке и сквозняки не позволяли создать идеально контролируемую среду. Ученый ушел в отпуск и оставил чашки Петри в раковине. Вместо того, чтобы просто вымыть их, как поступили бы многие ученые, он в первую очередь осмотрел их и нашел очаги с мертвыми бактериями, подобные тем, что получились от капли слизи с лизоцимом. Но теперь ореол ингибирования появился вокруг некоторых грибков, которые высадились на чашках – споры попали туда через трещины в потолке с нижнего этажа, где также проводился эксперимент.
Споры попали в чашки Петри в самый подходящий момент: в период, когда температура была идеальна. Если бы бактерии в чашках находились в другой фазе своего развития, грибок не оказал бы на них никакого влияния.
Флеминг понял, что эта плесень способна убивать бактерии. Однако лишь в 1940-х годах другая группа ученых выполняла различные эксперименты, используя грибок на мышах. Они выяснили, что плесень может выжить в организме млекопитающего, и что пенициллин имеет потенциал для лечения бактериальных инфекций у человека. Они не собирались исследовать его использование – открытие стало чистой случайностью.
Это одна из причин, по которым доктор Бейтман хочет продолжать работать над исследованием совпадений: осведомленность и восприимчивость может помочь людям чаще замечать полезные совпадения. Если бы та лаборатория была в лучшем состоянии, споры никогда бы не попали в раковину Флеминга. Если Флеминг не был так скрупулезен, решив изучить грибок в раковине, перед тем как его смыть, он бы не заметил ореол ингибирования. Если бы споры не приземлились в нужное время, Флеминг не сделал бы своего открытия.
Таким образом, многие совпадения вкупе с некоторой проницательностью привели к открытию того, что спасло миллионы жизней.

Обозреватель научно-популярного журнала Scientific American скептик доктор Майкл Шермер описал случай из собственной жизни, который изумил его, и в котором фигурировал транзисторный приемник покойного деда его жены.
Доктор Бернард Бейтман является отцом-основателем Coincidence Studies. В рамках программы Университета Вирджинии он разрабатывает терминологию и методику для изучения совпадений, и в целом делает этот увлекательный феномен, по его словам, “более наукообразным”.
Он слышал огромное множество историй о совпадениях и делится многими из них в ходе своих исследований. Вот несколько особенных примеров.
1. Судьбоносная находка
Когда журналист Стивен Даймонд приехал в Сан-Франциско, у него в кармане было всего 10 долларов. Он не мог позволить себе даже блокнот для записей, а тем временем вдохновение било через край. Он решил, было, украсть блокнот, но передумал. Внезапно он заметил то, в чем так сильно нуждался: блокнот, лежащий лицевой стороной вниз на груде мусора, одежды, обуви, старых книг. Заголовок на блокноте гласил “Стивен Даймонд, Доктор Медицины”. Каковы были шансы Даймонда найти в мусоре блокнот с собственным именем на обложке, да еще в идеальном состоянии, когда он больше всего был нужен? Так в свет вышел культовый роман “What the Trees Said”.
2. Невероятное совпадение поражает скептика

Доктор Майкл Шермер является основателем журнала Skeptic, исполнительным директором организации Skeptics Society и ежемесячным обозревателем журнала Scientific American. Он написал в своей колонке 16 сентября о неком событии, которое привело его к выводу, что не следует закрывать свое восприятие, ведь оно может подарить нам удивительные открытия.
Багаж его невесты был переправлен в Соединенные Штаты из Германии, и среди прочего там был старый транзисторный радиоприемник ее дедушки. Девушка была очень близка со своим дедом, который умер, когда ей было 16. Радио молчало на протяжении десятилетий, и Шермер, как ни старался, не мог заставить его снова заработать. Оно по-прежнему хранило молчание глубоко в ящике стола в спальне супругов. В июне этого года они поженились. После церемонии жена Шермана попросила его поговорить с ней наедине. Она чувствовала себя одиноко, скучала по своей семье в Германии и жалела, что дедушка не дожил до свадьбы и не смог выдать ее замуж. Внезапно из глубины дома молодые услышали музыку, это была романтическая мелодия. Они тщетно искали источник музыки, и вдруг его жена испуганно взглянула на него. ‘Это не может быть то, о чем я думаю, правда?’ – спросила она. Это был транзисторный радиоприемник в ящике. “Мой дедушка здесь с нами”, – сказала она, со слезами на глазах. “Я не одна”. Радио продолжало работать всю брачную ночь.
“Что примечательно, наутро оно перестало играть и молчит по сей день,” пишет Шермер.
3. В нужное время в нужном месте
Александр Флеминг, открывший пенициллин. (фон: чашка Петри с плесенью )
Пенициллин, антибиотик, совершивший огромный прорыв в борьбе с бактериальными инфекциями, был обнаружен после многих лет благодаря многим случайностям и совпадениям.
Шотландский бактериолог Александр Флеминг был простужен в ноябре 1921 года. От насморка с его носа упала капля прямо в чашку для культивирования, полную бактерий. Ученый понял, что эта капля убила бактерии и оставила вокруг себя ореол ингибирования. Компонентом той слизи, что убила бактерии, был лизоцим, однако его нельзя было массово производить в качестве антибиотика.
Почти десять лет спустя Флеминг проводил исследования в больнице Святой Марии. Лабораторные условия были неудовлетворительны – трещины в потолке и сквозняки не позволяли создать идеально контролируемую среду. Ученый ушел в отпуск и оставил чашки Петри в раковине. Вместо того, чтобы просто вымыть их, как поступили бы многие ученые, он в первую очередь осмотрел их и нашел очаги с мертвыми бактериями, подобные тем, что получились от капли слизи с лизоцимом. Но теперь ореол ингибирования появился вокруг некоторых грибков, которые высадились на чашках – споры попали туда через трещины в потолке с нижнего этажа, где также проводился эксперимент.
Споры попали в чашки Петри в самый подходящий момент: в период, когда температура была идеальна. Если бы бактерии в чашках находились в другой фазе своего развития, грибок не оказал бы на них никакого влияния.
Флеминг понял, что эта плесень способна убивать бактерии. Однако лишь в 1940-х годах другая группа ученых выполняла различные эксперименты, используя грибок на мышах. Они выяснили, что плесень может выжить в организме млекопитающего, и что пенициллин имеет потенциал для лечения бактериальных инфекций у человека. Они не собирались исследовать его использование – открытие стало чистой случайностью.
Это одна из причин, по которым доктор Бейтман хочет продолжать работать над исследованием совпадений: осведомленность и восприимчивость может помочь людям чаще замечать полезные совпадения. Если бы та лаборатория была в лучшем состоянии, споры никогда бы не попали в раковину Флеминга. Если Флеминг не был так скрупулезен, решив изучить грибок в раковине, перед тем как его смыть, он бы не заметил ореол ингибирования. Если бы споры не приземлились в нужное время, Флеминг не сделал бы своего открытия.
Таким образом, многие совпадения вкупе с некоторой проницательностью привели к открытию того, что спасло миллионы жизней.
Только зарегистрированные и авторизованные пользователи могут оставлять комментарии.
0
Еще фактов, интересно
- ↓
0
Есть и еще, сегодня выложу)))
- ↑
- ↓

